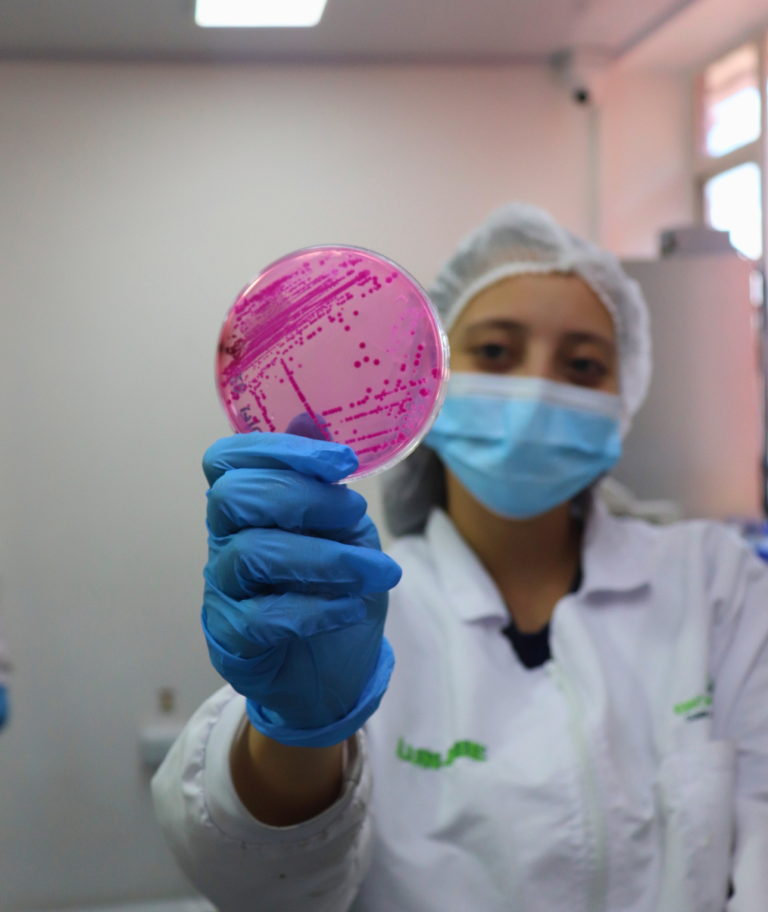

Laboratorio
de Análisis de
Aguas y Alimentos
En Biopolab fusionamos la excelencia e innovación de nuestros servicios para ofrecer soluciones a la medida de su industria. Con un amplio portafolio de servicios y un equipo multidisciplinario compuesto por profesionales y expertos del más alto nivel, nos destacamos por nuestro compromiso con el servicio y enfoque para brindar la mejor experiencia a nuestros clientes.
Nuestras acreditaciones respaldan nuestro compromiso con la calidad y la precisión en cada servicio que ofrecemos, siendo así su mejor aliado estratégico de análisis, garantizando resultados precisos, oportunos, cumplimiento y calidad.

Nuestros servicios de análisis

Agua
Agua potable, agua envasada, agua de piscina agua industrial, agua tratada y test de jarras o tratabilidad

Ambiental
Aguas residuales, monitoreos, análisis de aire, fuentes fijas y ruido, aforos, hidrobiología, residuos peligrosos, y suelos

Alimentos
Análisis microbiológicos, fisicoquímicos, pesticidas, metales, vitaminas, tablas nutricionales, OMG y migración en empaques

Jabones
Análisis de la capacidad antimicrobiana, fósforo, biodegradabilidad y eficacia de detergentes en diversos espacios.

Cannabis
THC, análisis microbiológicos, detección de metales tóxicos, peligrosos y pesticidas.

Jabones
Análisis de la capacidad antimicrobiana, fósforo, biodegradabilidad y eficacia de detergentes en diversos espacios.
NUEVO SERVICIO
Análisis OGMs (Organismos Genéticamente Modificados)
Realizamos análisis para la detección de OGM en muestras para consumo humano, mediante la identificación de materias primas para consumo humano que los contengan.


- OTROS ANÁLISIS
- Metales pesados
- Etiquetado nutricional
- Estudios de estabilidad
- Vitaminas y conservantes
- Micotoxinas y contaminantes

Nuestro compromiso es con el Planeta
En Biopolab, estamos firmemente comprometidos con el cuidado del planeta y la promoción de prácticas ecológicas para preservar el medio ambiente. Desde el año 2008, hemos sido pioneros en la implementación de políticas y acciones sostenibles que fomentan el reciclaje y la reducción de nuestra huella de carbono. En Biopolab, creemos firmemente que nuestro compromiso con la sostenibilidad es un pilar esencial de nuestro éxito y una contribución significativa para el bienestar de las generaciones presentes y futuras.

Nuestras acreditaciones



¿Por qué debería analizar?
Conozca a grandes rasgos la importancia de analizar sus productos y sus impactos al ecosistema:

Los análisis microbiológicos y fisicoquímicos son una herramienta importante para la evaluación de la calidad e inocuidad en procesos de transformación alimentaria, y/o gestión ambiental de las organizaciones, actualmente el gobierno realiza a través de sus instituciones vigilancia frecuente sobre el cumplimento de las normas vigentes.
Los organismos de control vigilan con cercanía las actividades comerciales y el impacto ambiental producido por las empresas. Así mismo, analizar puede evitar enfermedades profesionales, multas económicas altas y en ocasiones, el cierre parcial o total del establecimiento comercial.
El control y los resultados amplían las posibilidades de tomar decisiones y ayudan a establecer relaciones comerciales, adquisición de nuevos clientes y el posicionamiento de la marca de cara al consumidor.

¿Listos para analizar?
Reciba asesoría profesional y personalizada para ofrecer productos de calidad a sus consumidores, al mismo tiempo que contribuye a la sostenibilidad del planeta.
BIONEWS
Noticias & Blog
Mantengase actualizado de lo que pasa alrededor, normas, leyes y acreditaciones para su empresa
Visitors May Receive Perks With Crypto Prizes. — United States Join the Action
The high bet prerequisite excogitate the cassino ‘s come near to endangerment direction just expect…
Prihlásiť Sa Nové Hry • Slovensko
Členovia Mohli By Obdržať Výhody V Angličtine. Návštevníci Mať Šancu Obdržať Propagácie Na Progresívnych Jackpotoch.…
Místní Trendy — česká oblast Try Your Luck
Kapesní Počítač Uživatelé Připojit Se Jackpot Aktivity Snadno Pomocí Na Jakémkoli Zařízení. Důvěryhodné Kasino Eddyvegas…
Información de contacto
Para ventas
- +57 315 811 8933 para Área administrativa
- +57 310 221 7580 para PQR´s
- +57 (601) 794 3455
- servicio.cliente@biopolab.com
- Cra. 49B #91-40 Barrio La Castellana Bogotá D.C, Colombia
